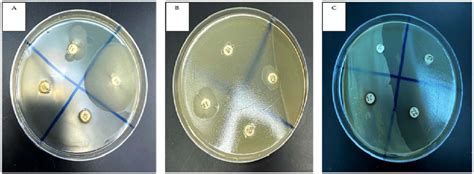

Bacterial Cell-Free Supernatant: Uses And Benefits
Bacterial Cell-Free Supernatant: Uses and Benefits
Let’s dive into the world of bacterial cell-free supernatant , guys! What exactly is it, and why should you care? Well, in simple terms, it’s the liquid left over after you remove bacterial cells from a culture. Think of it like brewing coffee – the supernatant is like the coffee, full of all sorts of goodies, while the bacterial cells are like the coffee grounds.
Table of Contents
What is Bacterial Cell-Free Supernatant?
Bacterial cell-free supernatant (BCFS) is the clear liquid obtained after removing intact bacterial cells from a bacterial culture. This removal is typically achieved through centrifugation or filtration, leaving behind a solution rich in various compounds secreted by the bacteria during their growth phase. These compounds can include proteins, enzymes, metabolites, signaling molecules, and even antimicrobial substances. Because BCFS contains a diverse array of bioactive molecules, it has garnered significant attention in various fields, including biotechnology, medicine, and agriculture. Understanding the composition and properties of BCFS is crucial for harnessing its potential applications.
The process of obtaining bacterial cell-free supernatant begins with culturing bacteria in a suitable growth medium. The choice of medium and growth conditions can significantly influence the composition of the resulting supernatant. Once the bacteria have grown sufficiently, the culture is centrifuged to separate the cells from the liquid medium. The supernatant is then carefully collected, often followed by filtration to ensure the complete removal of any remaining cells or debris. The resulting BCFS can be used directly or further processed to concentrate or purify specific components.
The composition of bacterial cell-free supernatant is highly variable and depends on several factors, including the bacterial species, growth medium, incubation conditions, and the stage of growth at which the supernatant is harvested. For example, some bacteria may secrete large amounts of proteins, while others may produce a diverse range of metabolites. Understanding the specific composition of BCFS is essential for tailoring its use to specific applications. Techniques such as mass spectrometry, chromatography, and enzyme assays are commonly used to analyze the composition of BCFS.
The properties of bacterial cell-free supernatant are closely linked to its composition. The presence of enzymes can confer catalytic activity, while antimicrobial substances can inhibit the growth of other microorganisms. Signaling molecules can influence cell behavior, and metabolites can provide nutrients or energy sources. The stability of BCFS is also an important consideration, as some components may degrade over time or under certain storage conditions. Proper handling and storage are therefore essential to maintain the activity and integrity of BCFS.
Applications of Bacterial Cell-Free Supernatant
Bacterial cell-free supernatant applications are wide and varied, ranging from medicine to agriculture. In medicine, it’s being explored for its potential as an antimicrobial agent, a wound-healing promoter, and even as an anti-cancer treatment. In agriculture, it can act as a biofertilizer or a biocontrol agent, helping plants grow stronger and healthier. Let’s explore some of the key applications:
1. Antimicrobial Applications
Bacterial cell-free supernatant (BCFS) has shown great promise as a source of antimicrobial agents. Many bacteria produce antimicrobial compounds, such as bacteriocins, which can inhibit the growth of other bacteria. BCFS containing these compounds can be used to combat bacterial infections, particularly those caused by antibiotic-resistant strains. The use of BCFS as an antimicrobial agent offers several advantages over traditional antibiotics. First, it can be more specific in its action, targeting only certain types of bacteria while leaving beneficial microbes unharmed. Second, it is less likely to promote the development of antibiotic resistance, as the antimicrobial compounds in BCFS often act through different mechanisms than traditional antibiotics. Third, BCFS can be produced relatively easily and inexpensively, making it a potentially valuable tool for combating infectious diseases.
The antimicrobial activity of BCFS can be assessed using various methods, such as disk diffusion assays, broth microdilution assays, and time-kill assays. These assays measure the ability of BCFS to inhibit the growth of bacteria in vitro. In vivo studies in animal models have also shown that BCFS can be effective in treating bacterial infections. For example, BCFS has been used to treat skin infections, wound infections, and respiratory infections in animals. Clinical trials are now underway to evaluate the safety and efficacy of BCFS in treating bacterial infections in humans.
The mechanisms of action of the antimicrobial compounds in BCFS are diverse and can include disruption of the bacterial cell membrane, inhibition of protein synthesis, and interference with DNA replication. Bacteriocins, for example, often form pores in the cell membrane, leading to cell death. Other antimicrobial compounds may target specific enzymes or metabolic pathways essential for bacterial growth. Understanding the mechanisms of action of these compounds is crucial for optimizing their use as antimicrobial agents.
2. Wound Healing
Bacterial cell-free supernatant can also play a significant role in wound healing. The components in BCFS, such as growth factors and extracellular matrix proteins, can promote cell proliferation, migration, and differentiation, all of which are essential for tissue regeneration. BCFS can also stimulate the production of collagen, a key component of the extracellular matrix that provides structural support to tissues. Furthermore, the antimicrobial properties of BCFS can help prevent infection, which is a major obstacle to wound healing.
Studies have shown that BCFS can accelerate wound healing in both in vitro and in vivo models. In vitro, BCFS has been shown to promote the migration of fibroblasts and keratinocytes, the cells responsible for wound closure. In vivo, BCFS has been shown to reduce inflammation, promote angiogenesis (the formation of new blood vessels), and accelerate the formation of granulation tissue, which is a key step in wound healing. Clinical trials are now underway to evaluate the safety and efficacy of BCFS in treating chronic wounds, such as diabetic ulcers and pressure sores.
The mechanisms by which BCFS promotes wound healing are complex and involve multiple signaling pathways. Growth factors in BCFS, such as epidermal growth factor (EGF) and transforming growth factor-beta (TGF-β), can bind to receptors on cells and activate intracellular signaling cascades that promote cell proliferation and migration. Extracellular matrix proteins, such as fibronectin and laminin, can provide a scaffold for cell attachment and migration. The antimicrobial properties of BCFS can help prevent infection and reduce inflammation, creating a more favorable environment for wound healing.
3. Anti-Cancer Properties
Interestingly, some studies suggest that bacterial cell-free supernatant might possess anti-cancer properties. Certain bacterial metabolites have been shown to inhibit the growth of cancer cells in vitro. While this area of research is still in its early stages, the potential for BCFS as an anti-cancer agent is intriguing.
The anti-cancer properties of BCFS are thought to be mediated by several mechanisms. Some bacterial metabolites can induce apoptosis (programmed cell death) in cancer cells. Others can inhibit angiogenesis, which is the formation of new blood vessels that supply tumors with nutrients. Still others can stimulate the immune system to attack cancer cells. The specific metabolites responsible for the anti-cancer activity of BCFS vary depending on the bacterial species and the type of cancer cell being studied.
In vitro studies have shown that BCFS can inhibit the growth of a variety of cancer cell lines, including breast cancer, colon cancer, lung cancer, and leukemia cells. In vivo studies in animal models have also shown that BCFS can reduce tumor growth and metastasis. However, more research is needed to determine the safety and efficacy of BCFS as an anti-cancer agent in humans. Clinical trials are now underway to evaluate the potential of BCFS in treating cancer.
4. Agricultural Applications
In agriculture, bacterial cell-free supernatant is gaining recognition as a biofertilizer and biocontrol agent. The metabolites and signaling molecules present in BCFS can promote plant growth and enhance the plant’s natural defenses against pathogens. This can lead to increased crop yields and reduced reliance on chemical pesticides and fertilizers.
BCFS can promote plant growth by providing essential nutrients, such as nitrogen, phosphorus, and potassium. It can also stimulate the production of plant hormones, such as auxins and cytokinins, which regulate plant growth and development. Furthermore, BCFS can improve soil structure and increase the availability of nutrients to plants. As a biocontrol agent, BCFS can inhibit the growth of plant pathogens, such as fungi and bacteria. It can also induce systemic resistance in plants, making them more resistant to future infections.
Studies have shown that BCFS can increase crop yields in a variety of crops, including wheat, rice, corn, and soybeans. It can also reduce the incidence of plant diseases and pests. The use of BCFS in agriculture offers several advantages over traditional chemical fertilizers and pesticides. First, it is more environmentally friendly, as it does not pollute the soil or water. Second, it is less likely to harm beneficial insects and other organisms. Third, it can improve the quality of crops, making them more nutritious and flavorful.
Benefits of Using Bacterial Cell-Free Supernatant
So, why should we be excited about using bacterial cell-free supernatant ? Well, it offers several advantages:
- Natural and Sustainable: BCFS is derived from bacteria, making it a natural and sustainable alternative to synthetic compounds.
- Broad Spectrum of Activity: Depending on the bacteria, BCFS can have a wide range of activities, from antimicrobial to growth-promoting.
- Cost-Effective: Producing BCFS is relatively simple and inexpensive, making it accessible for various applications.
- Reduced Risk of Resistance: Unlike traditional antibiotics, BCFS may be less likely to induce resistance in bacteria.
Challenges and Future Directions
While the potential of bacterial cell-free supernatant is enormous, there are challenges to overcome. Standardizing the production and composition of BCFS is crucial to ensure consistent results. Further research is needed to fully understand the mechanisms of action of the various components in BCFS. And, of course, rigorous testing is essential to ensure its safety and efficacy for different applications.
Looking ahead, the future of BCFS research is bright. As we continue to unravel the complexities of the microbiome and the interactions between bacteria and their environment, we can expect to see even more innovative applications of BCFS emerge. From personalized medicine to sustainable agriculture, bacterial cell-free supernatant has the potential to revolutionize various fields and improve our lives.
So, there you have it, guys! A glimpse into the fascinating world of bacterial cell-free supernatant. Keep an eye on this area of research – it’s sure to bring exciting developments in the years to come! I hope you found this helpful and informative!